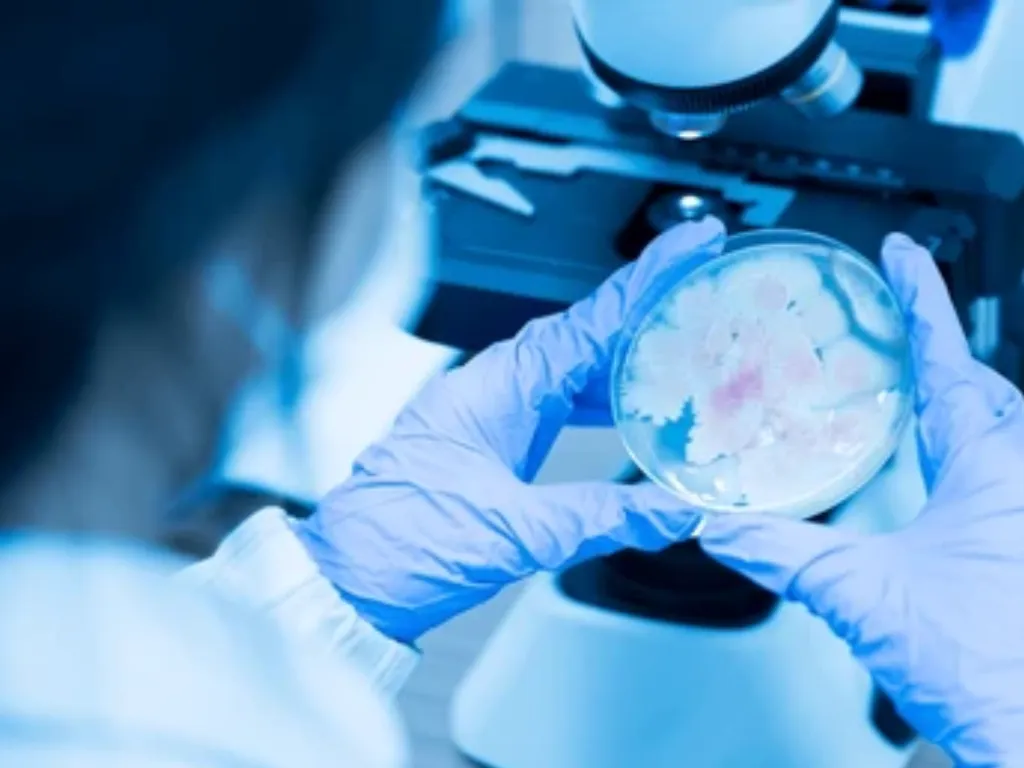

Protein Sciences & Molecular Biology
- Home
- »
- Protein Sciences & Molecular Biology


Proteins are fundamental biomolecules that perform diverse and critical functions in living organisms, including enzymatic catalysis, cellular signaling, immune responses and structural support.
In biologics development, understanding protein structure, function and expression is essential to design effective therapeutic candidates. Molecular biology techniques enable precise manipulation of genes and expression systems to produce high-quality recombinant proteins tailored for clinical applications.
Transient Protein Expression & Purification
Rapid generation of proteins through transient expression systems accelerates early-stage drug discovery and antibody development. Anthem offers transient expression services using both mammalian and microbial hosts, coupled with advanced purification methods such as affinity chromatography and size-exclusion chromatography.
This approach delivers high-purity proteins suitable for structural studies, in vitro assays, and preclinical evaluation, enabling faster decision-making in drug development.
Host Selection for Protein Expression
Choosing the right host system is critical for successful protein production. Factors influencing host selection include protein complexity, post-translational modification requirements, yield expectations and scalability.
Microbial Systems
- Escherichia coli and Bacillus subtilis for rapid, cost effective expression of simple proteins.
- Yeasts like Pichia pastoris and Saccharomyces cerevisiae for secreted proteins with some post-translational modifications.

Mammalian Systems
- CHO, HEK293 and Sp2/0 cells for complex glycosylated proteins such as monoclonal antibodies and fusion proteins.
Strain & Expression Enhancement
To maximize protein yield and maintain functionality, Anthem employs advanced strain engineering and expression optimization techniques. These strategies ensure robust, scalable protein production with consistent quality.
01.
Gene amplification and codon optimization to enhance translation efficiency.
02.
Use of specialized expression vectors incorporating regulatory elements for stable, high-level expression.
03.
Metabolic engineering to improve host cell productivity and protein folding.
Molecular Biology Services
Our molecular biology expertise supports the entire protein development pipeline. These services enable the creation of superior therapeutic candidates with enhanced efficacy and manufacturability.
Site-Directed Mutagenesis
Precise modification of protein sequences to improve stability, activity or binding properties.
Gene Synthesis & Cloning
Custom design and synthesis of genes optimized for expression in chosen hosts.
Vector Construction
Development of tailored expression vectors to maximize protein yield and stability.
